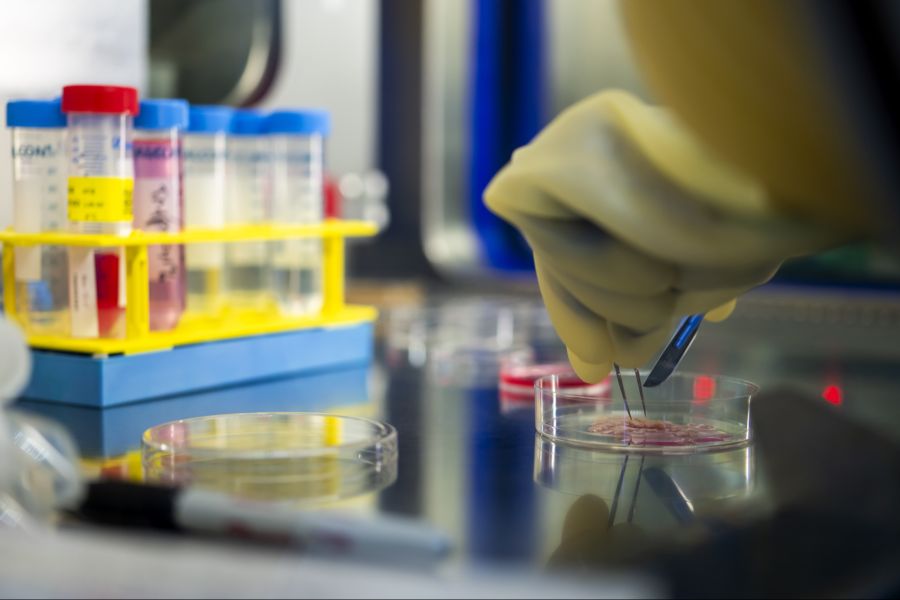
Eine Studie hat nun untersucht, welche Patientinnen und Patienten besonders gefährdet sind, eine solche Infektion zu entwickeln.
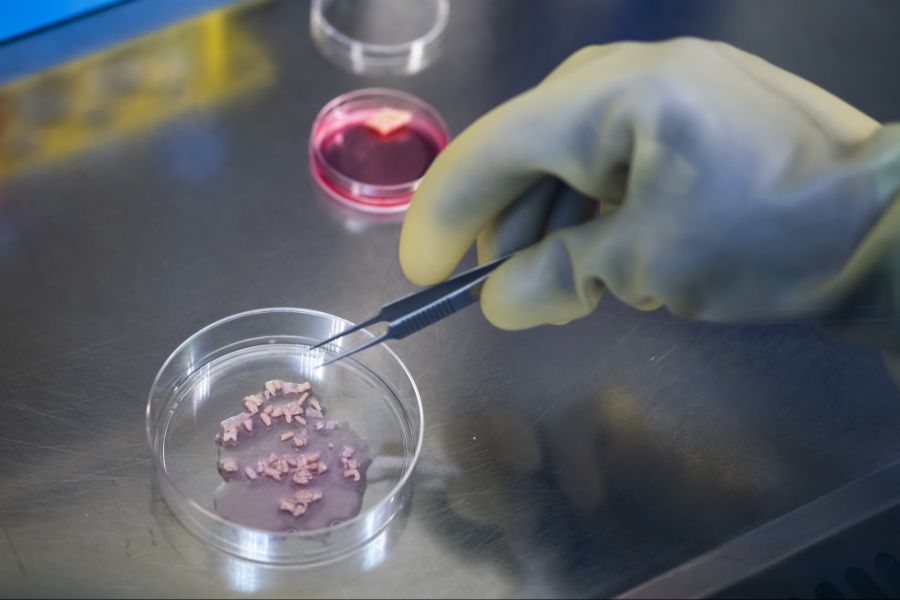
In einer Folgestudie werden die gesammelten Proben auf Geschlechtshormone und die Zusammensetzung des Mikrobioms von Haut und Atemwegen untersucht. (Symbolbild)

Geschlechterunterschied bei Brandverletzungen überrascht Forschung
Frauen mit schweren Verbrennungen erleiden laut einer Studie fast doppelt so häufig Blutinfektionen wie Männer.

Das Wichtigste in Kürze
- Bei schweren Verbrennungen erleiden Frauen deutlich häufiger Blutinfektionen als Männer.
- Warum Frauen anfälliger sind, können Forschende noch nicht beantworten.
- Eine Hypothese ist, dass die Verbrennungen den Hormonstoffwechsel verändern könnten.
Bei schweren Brandverletzungen können Bakterien über die zerstörte Haut in den Blutkreislauf gelangen und lebensgefährliche Komplikationen auslösen.
Gemäss einer Mitteilung des Schweizerischen Nationalfonds (SNF) vom Mittwoch kann dies eine sogenannte Sepsis auslösen. Und diese kann dann zu multiplem Organversagen führen.
Eine vom SNF finanzierte Studie hat nun untersucht, welche Patientinnen und Patienten besonders gefährdet sind, eine solche Infektion zu entwickeln.
Die Analyse umfasste 269 Personen, die zwischen 2017 und 2021 im Zentrum für Schwerbrandverletzte am Universitätsspital Zürich (USZ) behandelt wurden.
Die Auswertung der Daten zeigte: Bei knapp einem Viertel der Betroffenen wurden fünf bis dreizehn Tage nach der Einlieferung Bakterien im Blut nachgewiesen. Dabei waren Frauen fast doppelt so häufig betroffen wie Männer.
Grund für Geschlechterunterschied noch nicht klar
Dieses Ergebnis sei überraschend, wird Silvio Brugger, leitender Oberarzt am USZ, in der Mitteilung zitiert.
Normalerweise seien Blutstrominfektionen bei Frauen seltener als bei Männern. Oft komme das weibliche Immunsystem besser mit Krankheitserregern zurecht.
Bei Brandverletzungen scheint dies jedoch nicht der Fall zu sein. Veröffentlicht wurden die Resultate in der neuesten Ausgabe der Fachzeitschrift «Burns».
Warum Frauen in der untersuchten Gruppe anfälliger waren, können die Forschenden noch nicht beantworten.
Unterschiede bei den Krankheitserregern scheiden als Erklärung aus. Bei beiden Geschlechtern wurden vorwiegend dieselben Bakterienarten gefunden, die normalerweise harmlos auf der Haut oder in der Mundhöhle leben.
In einer Folgestudie sollen nun die gesammelten Proben auf Geschlechtshormone untersucht werden. Zudem wird die Zusammensetzung des Mikrobioms von Haut und Atemwegen untersucht.
Eine Hypothese der Forschenden ist, dass die Verbrennungen den Hormonstoffwechsel verändern und dadurch die Immunantwort schwächen könnten. Normalerweise werden weibliche Geschlechtshormone wie Östrogen mit einer besseren Immunreaktion in Verbindung gebracht.